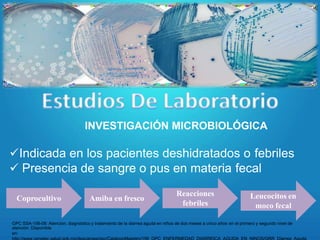
INVESTIGACIÓN MICROBIOLÓGICA
Indicada en los pacientes deshidratados o febriles
 Presencia de sangre o pus en materia fecal
Coprocultivo Amiba en fresco
Reacciones
febriles
Leucocitos en
moco fecal
GPC SSA-156-08: Atención, diagnóstico y tratamiento de la diarrea aguda en niños de dos meses a cinco años en el primero y segundo nivel de
atención. Disponible
en:

La enfermedad diarreica aguda en niños se define como la expulsión de tres o más deposiciones líquidas en 24 horas. Es causada principalmente por rotavirus y puede provocar deshidratación. Los síntomas incluyen cambios en la consistencia y frecuencia de las evacuaciones, así como náusea y vómito. El diagnóstico se basa en el contexto clínico y epidemiológico, y se realizan pruebas microbiológicas solo en casos específicos.